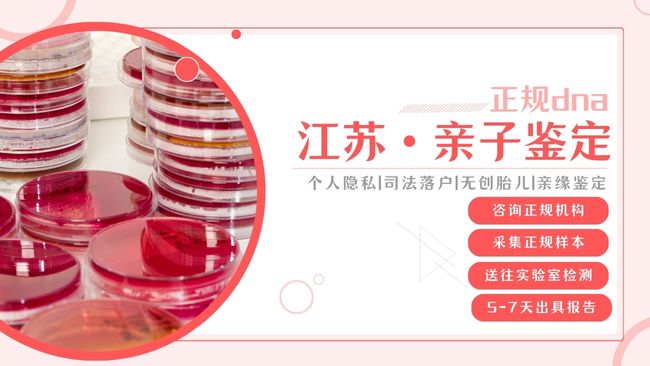

常州哪里能做親子鑒定
在常州,若需進(jìn)行親子鑒定樣本采樣,常州本地部分三甲醫(yī)院可協(xié)助采樣,但具體鑒定業(yè)務(wù)需與專業(yè)機(jī)構(gòu)合作。中量親鑒基因親子鑒定機(jī)構(gòu)位于常州市天寧區(qū)晉陵中路517號。醫(yī)生整理了可提供親子鑒定咨詢的機(jī)構(gòu)信息,排名不分先后,部分醫(yī)院能否開展親子鑒定需根據(jù)其業(yè)務(wù)范圍判斷,以下信息希望能為大家提供幫助。
一、常州親子鑒定機(jī)構(gòu)信息
常州中量親鑒親子鑒定咨詢中心
地址與交通:常州市天寧區(qū)晉陵中路517號
核心咨詢服務(wù):?
上戶口親子鑒定:詳細(xì)說明戶籍部門對鑒定報告的具體要求,例如是否必須現(xiàn)場采樣、需要提供哪些類型的證件,避免因流程不匹配而耽誤戶口辦理事宜。?
個人隱私親子鑒定:講解怎樣自行采集樣本(像毛發(fā)、口腔拭子這類常見樣本),包括樣本采集的規(guī)范操作、樣本保存的有效方法,以及全面周到的隱私保護(hù)措施,讓你能在不暴露個人身份的前提下順利完成鑒定。?
無創(chuàng)胎兒親子鑒定:解答孕期進(jìn)行檢測的適宜時間段(從孕6周開始就可以檢測)、檢測的安全性保障,還有孕婦樣本(靜脈血)和男方樣本(如煙頭、牙刷)的采集注意事項(xiàng)和規(guī)范要求。?
服務(wù)范圍:除了常州市內(nèi)的天寧區(qū)、鐘樓區(qū)、新北區(qū)、武進(jìn)區(qū)、金壇區(qū)、溧陽市等區(qū)縣,江蘇省內(nèi)其他城市的用戶也可通過線上平臺進(jìn)行咨詢,工作人員會耐心細(xì)致地解答各類疑問。?
機(jī)構(gòu)優(yōu)勢:作為專業(yè)的咨詢預(yù)約平臺,實(shí)時掌握先進(jìn)的鑒定技術(shù)和政策動態(tài)。?
咨詢內(nèi)容:針對移民申請、遺產(chǎn)繼承等特殊場景下的親子鑒定需求,告知所需的具體鑒定類型、報告的有效期限,以及如何與相關(guān)部門進(jìn)行對接;還會依據(jù)你的預(yù)算和時間安排,為你推薦合適的鑒定機(jī)構(gòu)和檢測周期。?

二、常州正規(guī)鑒定機(jī)構(gòu)名冊
1、常州中量親鑒天寧區(qū)親子鑒定采樣中心
地址:常州市天寧區(qū)局前街
2、常州中量親鑒天寧區(qū)親子鑒定采樣中心
地址:常州市天寧區(qū)興隆巷
3、常州中量親鑒鐘樓區(qū)親子鑒定采樣中心
地址:常州市鐘樓區(qū)棕櫚路
4、常州中量親鑒武進(jìn)區(qū)親子鑒定采樣中心
地址:常州市武進(jìn)區(qū)健身廣場對面
5、常州中量親鑒新北區(qū)親子鑒定采樣中心
地址:常州市新北區(qū)紅河路
6、常州中量親鑒金壇區(qū)親子鑒定采樣中心
地址:常州市金壇區(qū)金壇大大
7、常州中量親鑒溧陽市親子鑒定采樣中心
地址:溧陽市建設(shè)西路
聲明:部分采樣中心已關(guān)閉,請咨詢客服獲取采樣中心名單。以上機(jī)構(gòu)信息來源網(wǎng)絡(luò),皆為讀者提供更多信息咨詢,所涉內(nèi)容不構(gòu)成辦理、咨詢建議;如任何單位或個人認(rèn)為文章內(nèi)容涉嫌侵犯其合法權(quán)益,可及時留言提出意見并提供相關(guān)證明材料和理由,在收到后將采取相應(yīng)措施。
常州親子鑒定費(fèi)用說明
常州與正規(guī)醫(yī)院合作的親子鑒定機(jī)構(gòu)按類型收費(fèi),價格公開透明:
司法親子鑒定:費(fèi)用為2400-3000元(父子/女二聯(lián)體)或3000元(父母子三聯(lián)體),包含法律效力報告。
個人隱私親子鑒定:費(fèi)用為2000-2200元,支持匿名郵寄樣本,3-5個工作日出結(jié)果。
無創(chuàng)胎兒親子鑒定:費(fèi)用為3600-4200元,適用于孕6周以上孕婦靜脈血檢測,無流產(chǎn)風(fēng)險。
費(fèi)用浮動因素:樣本類型(如特殊樣本指甲需加收500元)、加急服務(wù)(24小時出報告需加價1000元)。
常州親子鑒定可選擇的正規(guī)機(jī)構(gòu)
目前,能做司法親子鑒定和個人鑒定的機(jī)構(gòu)主要有以下兩種情況,可根據(jù)具體需求選擇:
司法鑒定所或司法鑒定中心:可進(jìn)行司法親子鑒定,鑒定報告具有法律效力,可用于上戶口、遷戶口、打官司、移民等公證類事項(xiàng)。
基因公司或第三方鑒定機(jī)構(gòu):可進(jìn)行個人用途的隱私親子鑒定,如無創(chuàng)胎兒親子鑒定等,鑒定結(jié)果僅供個人私下了解,不具備法律效力。

常州親子鑒定流程介紹
司法鑒定四步流程:
委托與預(yù)約:提交身份證件及關(guān)系聲明書(由法院或派出所出具)。
身份核驗(yàn):攜帶證件原件到場,拍照并錄入指紋(未成年人需監(jiān)護(hù)人陪同)。
樣本采集:工作人員抽取指尖血(特殊樣本如口腔拭子需提前備案)。
報告簽發(fā):3-5個工作日內(nèi)出具含司法章及防偽碼的報告。
常州親子鑒定中心在哪里?選擇正規(guī)實(shí)體機(jī)構(gòu)可避免樣本郵寄污染風(fēng)險。
常州哪些醫(yī)院可協(xié)助親子鑒定采樣?常州本地部分三甲醫(yī)院可協(xié)助采樣,但大多數(shù)三甲醫(yī)院并不直接進(jìn)行親子鑒定??汕巴辛坑H鑒基因親子鑒定中心,地址在常州市梁溪區(qū)興源北路600號。親子鑒定作為一項(xiàng)嚴(yán)謹(jǐn)?shù)目茖W(xué)技術(shù),通過DNA比對能準(zhǔn)確判定親子關(guān)系。建議選擇具備司法鑒定資質(zhì)的正規(guī)機(jī)構(gòu),這些機(jī)構(gòu)嚴(yán)格遵循《司法親子鑒定程序通則》等法律法規(guī),執(zhí)行標(biāo)準(zhǔn)化操作流程,確保每份鑒定報告都真實(shí)可靠,可滿足司法訴訟、落戶申報等各類需求。
